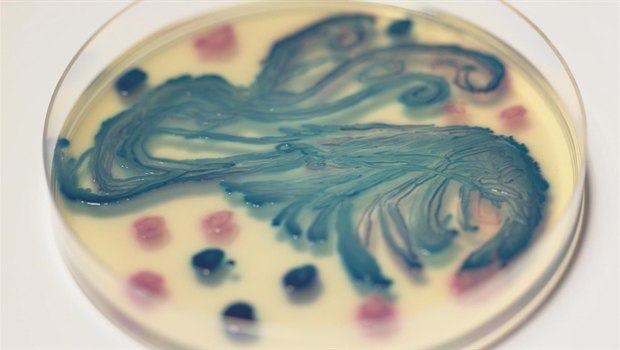
20190315_15526846358699.png WeChat Image_20190315134734.png

和吃鱼比起来,加拿大人平时更喜欢吃虾。虾是所有甲壳类水产中最受欢迎的,华人吃虾尤其讲究迅速起锅以保口感鲜嫩。
加拿大每年从都要进口价值7亿加元的虾,这些进口虾多数来自印度、越南、中国和泰国。很少有人知道这些进口虾是否安全,温哥华一家专营海鲜的超市鱼部厨师Clark说:我已经有20年没有吃过超市里卖的进口虾了,因为这些虾里充满了杀虫剂和抗生素。

根据加拿大广播电视台CBC昨日播出的调查报道《Marketplace》,加拿大市面上的进口虾,含有的抗生素耐药细菌水平令人担忧。
加拿大每年的进口虾产品约7亿元,其中大部分来自印度、越南、中国及泰国等亚洲国家。

检查结果让人担忧
记者从多伦多、卡尔加里、蒙特利尔和萨斯卡通四个城市的超市购得51袋不同产地和牌子的冷冻虾,送到萨斯喀彻温大学兽医微生物学系的实验室进行检测,其中包括解冻即食的熟冻虾。结果显示,51袋虾当中有14袋发现一种或多种细菌。近17%,被发现持有各种细菌。被发现问题的都是养殖虾,野生虾都没有问题,还有一袋是冷冻的熟虾。这九袋冷冻虾有5袋来自印度,2袋来自中国,1袋来自泰国,1 袋来自越南。当中有3袋虾持有ESBL超级细菌,一旦入侵人体,ESBL会感染人体内其他的细菌,令它们也对抗生素产生抗性。
在发现细菌的样品中,有一袋是熟冻虾。
有机(organic)海鲜或者认证食品可以确保安全吗?检查结果显示,这些产品也不能幸免。
4种有机产品中有1种被检测出含有对三种不同的抗生素类药物具有多重耐药性的细菌。
抗生素耐药细菌是什么?
细菌如果大量、频繁地接触抗生素,就会逐渐产生耐药性,产生耐药性的细菌将会更难被杀死。
据报道,全世界每年售出的抗生素,有80%是被禽畜养殖业和水产养殖业买走的。养殖场为了防止传染病蔓延,在动物的饲料里加入抗生素,有的地方还用喷洒抗生素的方式杀菌。
魁北克省公共卫生研究所实验室的里沙.马尚(Richard Marchand)表示,虾身上的细菌接触到的抗生素一方面来自虾饲料,另一方面来自水里的人类医用抗生素残余。
一般虾有细菌,也是正常的事。在这批有问题的虾中,发现的大肠杆菌和金黄色葡萄菌已经对抗生素产生耐药性,即抗生素也无法将它们杀死。
这些细菌也被称为超级细菌,超级细菌(superbug)不是特指某一种细菌,而是泛指那些对多种抗生素具有耐药性的细菌。这类细菌能对抗生素有强大的抵抗作用,能逃避被杀灭的危险。
McMaster大学传染病专家Gerry Wright博士表示,应该非常关注在食物链中出现的超级细菌问题;他表示,对这些东西感到害怕,可能是我们对21世纪现代医学的最大威胁。
在监管不严格的国家,抗生素被大量使用。用来养虾的河水或池塘已经被人类排出体外的抗生素残余污染。如果养殖场再用抗生素防病消毒,有可能将令一些细菌逐步从单一耐药到多重耐药甚至泛耐药,最终成为拥有金刚不败之身的超级细菌!
要杀死这些超级细菌,就是非常棘手的事了。
危害有多大?
英国研究人员2014年的一项研究进一步警告称,如果不加以控制,到2050年,抗生素耐药性的蔓延可能导致的死亡人数超过癌症。
在中国,媒体也多次报道超级细菌的危害,即使是年轻力强的青少年,在感染了超级细菌后也要抢救多周才能救回。
加拿大公共卫生署(PHAC)表示,发现结果“令人担忧”,因为发现的抗性基因“可以在细菌之间移动”。
PHAC表示,即使细菌通常不会引致人类感染,但亦存在“基因可能转移至更容易引起感染的细菌风险”。
抗生素耐药性被世界卫生组织称为全球健康面临最大威胁之一,估计每年全球有70万人因抗生素耐药性疾病而死亡。
在加拿大,BC省居民乔治患有结肠癌,又不幸在BC省一家医院做检查时从受污染的内窥镜中感染了一种对抗生素耐药的超级细菌。尽管用强大的抗生素攻击细菌,导致乔治产生幻觉,但感染仍然存在。
乔治在一年多里住了23次院,身体虚弱,无法继续接受癌症治疗,也无力进食。最终去世。
进口监管存在漏洞
加拿大政府对国内禽畜养殖业的抗生素使用是有一套监管制度的,非常严格地限制使用抗生素。但是对从国外进口的虾和其他水产,目前加拿大还没有任何检查细菌耐药性的措施。因此学界对加拿大卫生部要把进口水产纳入监管范围的呼声也很高。
【关键】如何防止被耐药细菌感染?
记者采访全球水产养殖联盟和相关的进口虾公司时,他们都表示,如果煮熟得当,他们的虾是安全的,因为任何细菌都会被杀死。一些公司表示,耐抗生素的细菌可能是受污染的土壤或水,或虾的加工和处理过程中产生的。
加拿大零售商委员会则表示,目前市面上出售的虾并没有违反加拿大的有关规定。虾里有耐药细菌并不罕见,但只要煮熟了就对健康无害。
据了解,大部分细菌存在于虾的身体表面,因此冷冻虾解冻后,不论生熟都要好好清洗。参与检测的专家表示,即使是耐药病菌也可以被高温杀死,所以要让虾完全熟了再起锅,切勿为了口感而吃半生熟的虾。
别以为虾做熟了就可以消灭所有细菌了,处理生虾时也要注意卫生,处理虾最好像处理生肉一样注意清洁,把它们和熟食分开,及时清洗案板、器皿、刀具和手,以免从这些渠道感染细菌。处理过生虾的器皿和手都要清洗消毒,这些地方都可以被细菌污染。
另外,参与调查的记者之一Denis Gagné说,这次所有被查出病菌的冷冻虾无一例外都是养殖虾。在他们送去检测的51袋样品中,野生虾都没有问题。
|
a
尽量购买当地海产品,避免中国养殖水产品。
- [157] (2019-03-16 21:27:47)
|